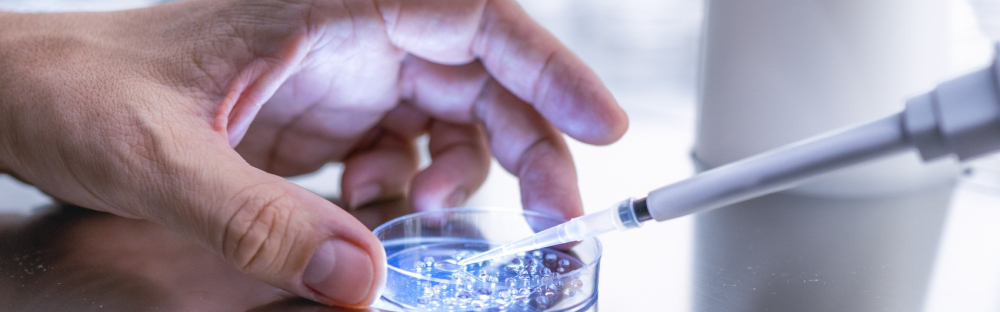
94135e093c44-C-Suite-barometer-life-sciences-pharma-webpage-header-1200x627.jpg

Surveys
Read more
Compliance, accuracy and visibility: the 3 non-negotiables in modern European payroll

How payroll evolved from a transactional necessity into a strategic pillar of organisational trust, data governance and people experience.
Harnessing the power of reporting & data insights

Discover how reporting, data and AI can move beyond compliance to become a catalyst for international growth
C-Suite-Barometer 2025: Sektorausblick Manufacturing

Globale Unsicherheiten verändern die Industrielandschaft, und produzierende Unternehmen stehen unter zunehmendem Druck, ihr Geschäftsmodell anzupassen und wettbewerbsfähig zu bleiben. Dennoch bleiben viele Top-Führungskräfte zuversichtlich, was ihre Wachstumsambitionen angeht. In diesem sich wandelnden Umfeld wird strategische Agilität zu einem entscheidenden Wettbewerbsvorteil. Unser aktueller Report C-Suite-Barometer Manufacturing gibt Einblick in die Pläne des C-Levels aus über 35 Ländern und Regionen und zeigt, wie führende Unternehmen der Fertigungsindustrie auf Veränderungen reagieren und wo sie neue Wachstumschancen erschließen.
Financial reporting of European banks: benchmark study 2025

As European banks move into 2025 amid renewed U.S. tariffs and heightened geopolitical tensions, is this calm before the storm? Throughout 2024, we observed a continued reduction in credit risk buffers, despite persistent macroeconomic pressures and geopolitical challenges. As we examine the year-end results of the region’s largest institutions, what do the figures reveal about how they manage expected credit losses (ECLs) in an increasingly unpredictable environment?
Analyse: Ist die CSRD die neue Messlatte im DAX?

Anders als erwartet wurde die europäische Corporate Sustainability Reporting Directive (CSRD) 2024 nicht mehr in deutsches Recht überführt. Mitten in der Berichterstellung mussten sich Unternehmen fragen: weiter mit dem Sustainability Statement nach CSRD oder zurück zu einer einfacheren nichtfinanziellen Erklärung? Unsere Analyse zeigt, welchen Weg die DAX 40 in ihrer Nachhaltigkeitsberichterstattung genommen haben, und was andere Unternehmen davon lernen können.
C-Suite-Barometer 2025: Sektorausblick Life Sciences und Pharma
In einem Jahr, das von globalen Unsicherheiten, steigenden regulatorischen Anforderungen und rapidem technologischen Wandel geprägt ist, definieren die Top-Führungskräfte ihre strategischen Prioritäten neu. Unser aktueller Report C-Suite-Barometer Life Sciences und Pharma gibt Einblick in die Pläne des C-Levels aus über 35 Ländern und Regionen und zeigt, wie die Marktteilnehmer mit komplexen Herausforderungen umgehen, in Wachstum investieren und sich für langfristigen Erfolg in einem wettbewerbsintensiven Geschäftsumfeld positionieren.
C-Suite-Barometer 2025: Sektorausblick Technologie-, Medien- und Telekommunikation

Von geopolitischen Unsicherheiten bis hin zu rasanten Fortschritten in der künstlichen Intelligenz – 2025 hat sich bereits jetzt als ein Jahr der Veränderungen und Umbrüche erwiesen. In diesem herausfordernden Umfeld ist strategische Agilität für Unternehmen im Technologie-, Medien- und Telekommunikationssektor (TMT) wichtiger denn je. Mit den Insights von Top-Führungskräften aus mehr als 35 Ländern zeigt unser aktueller Report, wie die TMT-Branche auf die sich wandelnden Rahmenbedingungen reagiert und wo Wachstumschancen liegen.
C-Suite-Barometer 2025: Sektorausblick Financial Services

In einem zunehmend komplexeren und schnelllebigeren Geschäftsumfeld legen Finanzdienstleister ihren Fokus auf strategische Transformation, resiliente Betriebsabläufe und darauf, relevante Skills der Mitarbeiter*innen für die Zukunft zu entwickeln. Unser aktueller Report C-Suite-Barometer Financial Services gibt Einblick in die Pläne der Top-Führungskräfte aus über 35 Ländern und Regionen und zeigt, wie sich Unternehmen der Branche an die aktuellen Veränderungen anpassen, Risiken und Chancen abwägen und ihre langfristigen Ziele neu definieren.
C-Suite-Barometer 2025: Cutting through competition

Weltweit richten Top-Level-Führungskräfte ihre Aufmerksamkeit auf neue Geschäfts- und Wachstumsmöglichkeiten in einem zunehmend wettbewerbsintensiven Umfeld. Zu diesem Ergebnis kommt die aktuelle Ausgabe unseres C-Suite-Barometers. Dafür wurden mehr als 1.700 C-Level-Führungskräfte aus über 35 Ländern und Regionen zu ihren strategischen Prioritäten befragt, sowie dazu, welche Markttrends und Veränderungen sie auf ihr Unternehmen zukommen sehen.
Global private equity report 2025

The international market may be volatile, but the outlook in the private equity (PE) sector shows increasing confidence. In this report, we uncover why PE firms remain optimistic for 2025 and what strategies they’re employing to drive investment.
So navigieren Sie sicher durch das komplexe Geflecht der Regulatorik

Das Geschäft zu internationalisieren ist oft der natürliche nächste Schritt für Unternehmen, um zu wachsen und sich zu diversifizieren. Doch die geopolitische, wirtschaftliche und technologische Landschaft befindet sich derzeit im ständigen Wandel und auch das regulatorische Umfeld wird immer unübersichtlicher. Diese Komplexität kann für Unternehmen, die in neuen Märkten Fuß fassen wollen, eine große Herausforderung darstellen.
M&A-Report – Sektoren Kosmetik und WPR

In dieser Studie berichtet Forvis Mazars in Deutschland über das M&A-Transaktionsgeschehen in den Branchen Kosmetik und WPR (Wasch-, Putz- und Reinigungsmittel) in der DACH-Region und in Europa.
M&A-Report Sektoren Land- und Baumaschinen

In dieser Studie berichtet Forvis Mazars in Deutschland über das M&A-Transaktionsgeschehen in den Branchen Baumaschinen sowie Landmaschinen (bzw. Landtechnik).
Analyse: auf dem Weg zur CSRD – DAX 40 im Fokus

In den letzten Jahren wurde viel zur CSRD diskutiert. Mit der herannahenden Berichtssaison 2025 wird es ernst: Dann sind die DAX-40-Unternehmen zum ersten Mal verpflichtet, Nachhaltigkeitsinformationen gemäß der CSRD offenzulegen. Unsere aktuelle Analyse der diesjährigen Nachhaltigkeitsberichte zeigt, dass die DAX 40 auf einem guten Weg sind, die neuen Standards zu erfüllen – auch wenn noch einige Hürden zu überwinden sind.
M&A-Report Food & Beverage

In dieser Studie berichtet Forvis Mazars in Deutschland über das M&A-Transaktionsgeschehen in der Lebensmittelindustrie (Food & Beverage bzw. F&B).
Resetting for a new era: Public and social sector-Studie 2024

Die Studie basiert auf den Aussagen von rund 400 Führungskräften des öffentlichen und sozialen Sektors. Sie zeigt, dass sich deren allgemeine Perspektiven und Prioritäten derzeit deutlich verändern, was auch auf einen strategischen Wandel hindeutet. Die Unternehmen sind sich bewusst, dass ihre Außenwahrnehmung immer wichtiger wird. In einer Zeit, in der qualifizierte Mitarbeiter*innen entscheidend dafür sind, dass neue Technologien erfolgreich ein- und umgesetzt sowie die Nachhaltigkeitsanforderungen übertroffen werden, sind Top-Manager*innen bestrebt, die Unternehmensresilienz weiter auszubauen.
Financial reporting of European banks: benchmark study 2024

Does the perceived reduction in risk amongst European banks hint at early signs of optimism for the sector? Throughout 2023, we observed a global economic slowdown, ongoing geopolitical tensions, and the rapid rise of new technologies. As we analyse the year-end results of the 26 largest banks in Europe, what do these figures reveal about expected credit losses and how these institutions manage persistent uncertainties in the banking landscape?
C-Suite-Barometer: Outlook 2024

2024 wird global ein Jahr des Aufbruchs sein: ein Jahr, in dem Unternehmen verstärkt in ihre Transformation und ihr Wachstum investieren. Zu diesem Ergebnis kommt die aktuelle Ausgabe der Studie C-Suite-Barometer, für die mehr als 800 C-Level-Führungskräfte aus 30 Ländern befragt wurden. Das Ziel war, von ihnen zu erfahren, wo sie ihre strategischen Prioritäten setzen und welche Markttrends und Veränderungen sie auf ihr Unternehmen zukommen sehen.
How do PE act on the performance of their portfolio? Pan-European PE survey

Wie tragen Finanzinvestoren zum Erfolg der Unternehmen in ihrem Portfolio bei? Dieser Frage ging Mazars in einer europaweiten Umfrage unter Private Equity (PE)-Gesellschaften Ende 2023 nach. Im Fokus lagen dabei die Performance-Entwicklung sowie die Maßnahmen zur Portfolio-Steuerung. Teilgenommen haben PE-Unternehmen aus acht Ländern mit aktiv und passiv gemanagten Portfolio-Gesellschaften wie auch mit Mehrheits- oder Minderheitsanteilen.